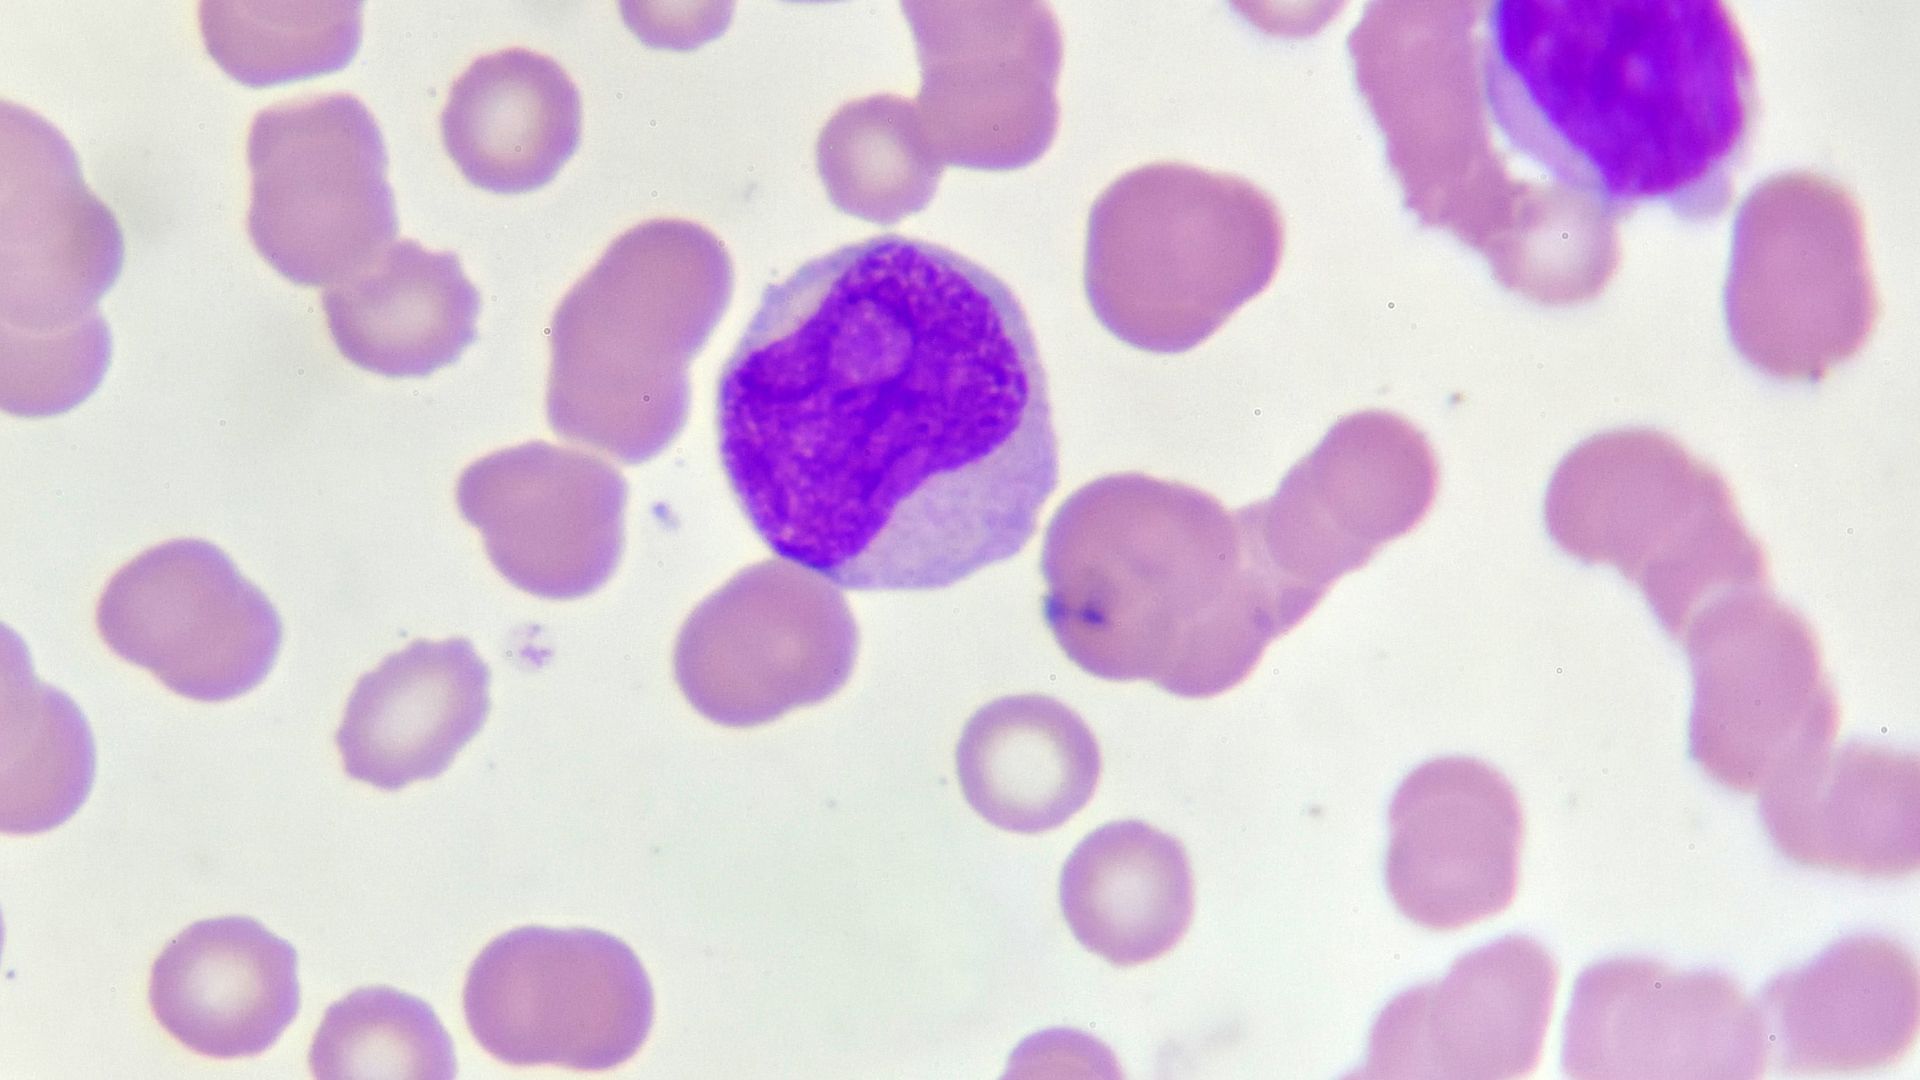
Bạch cầu cấp là một dạng ung thư máu do tế bào non phát triển và phân chia bất thường

Bạch cầu cấp là bệnh lý ác tính nguy hiểm, có thể gặp ở cả trẻ em và người lớn. Đây là căn bệnh khiến quá trình sản xuất tế bào máu bị rối loạn, làm suy yếu hệ miễn dịch và gây ra nhiều biến chứng nghiêm trọng. Hiểu rõ nguyên nhân, triệu chứng và phương pháp điều trị sẽ giúp người bệnh và gia đình chủ động hơn trong quá trình chăm sóc và phòng ngừa.
Bạch cầu cấp là gì?
Bạch cầu cấp là bệnh ung thư máu do tế bào non trong tủy xương phát triển và phân chia bất thường, lấn át tế bào máu khỏe mạnh. Khi đó, cơ thể không thể sản xuất đủ hồng cầu, bạch cầu lành và tiểu cầu, dẫn đến hàng loạt rối loạn nghiêm trọng trong hệ tạo máu.
Có hai nhóm chính của bệnh bạch cầu cấp:
- Bạch cầu cấp dòng lympho (ALL): Thường gặp ở trẻ em.
- Bạch cầu cấp dòng tủy (AML): Phổ biến ở người trưởng thành.
Cả hai thể đều có đặc điểm chung là tiến triển nhanh và có thể đe dọa tính mạng chỉ trong vài tháng nếu không được điều trị kịp thời. Khi tủy xương mất khả năng kiểm soát quá trình sinh sản tế bào máu, các tế bào non (blast) tăng sinh ồ ạt và không trưởng thành. Tình trạng này dẫn đến:
- Thiếu hồng cầu: Gây thiếu máu, mệt mỏi, da xanh xao.
- Thiếu tiểu cầu: Làm tăng nguy cơ xuất huyết.
- Giảm bạch cầu lành: Khiến cơ thể dễ nhiễm trùng.
Tất cả những rối loạn này tạo nên vòng luẩn quẩn làm suy kiệt khả năng miễn dịch và tăng nguy cơ biến chứng đe dọa tính mạng.
Nguyên nhân và triệu chứng của bệnh bạch cầu cấp
Dưới đây là nguyên nhân và triệu chứng của bệnh lý bạch cầu cấp, cụ thể như sau:
Nguyên nhân gây bệnh
Bệnh bạch cầu cấp hình thành do sự kết hợp của nhiều yếu tố. Mặc dù chưa thể xác định chính xác nguyên nhân cụ thể, song một số yếu tố nguy cơ dưới đây được cho có thể làm tăng nguy cơ mắc bạch cầu cấp:
- Di truyền: Người có tiền sử hội chứng Down, Fanconi hoặc Turner dễ mắc bệnh hơn do đột biến gen.
- Tác nhân phóng xạ: Tiếp xúc thường xuyên với tia X, tia gamma, hoặc từng điều trị ung thư bằng xạ trị.
- Hóa chất độc hại: Làm việc trong môi trường có benzen, formaldehyde hoặc thuốc trừ sâu.
- Tác dụng phụ thuốc: Một số thuốc hóa trị thuộc nhóm alkylating agents có thể kích hoạt bệnh bạch cầu cấp, đặc biệt là AML.
- Rối loạn máu tiền ung thư: Người mắc hội chứng rối loạn sinh tủy hoặc tăng sinh tủy mạn tính có thể tiến triển thành bạch cầu cấp.
Những yếu tố này không đồng nghĩa chắc chắn gây bệnh, nhưng là dấu hiệu cảnh báo cần được theo dõi sát trong các đợt khám sức khỏe định kỳ.

Triệu chứng nhận biết
Bệnh bạch cầu cấp thường diễn biến âm thầm, khiến nhiều người chỉ phát hiện khi bệnh đã ở giai đoạn tiến triển. Một số dấu hiệu dưới đây giúp nhận biết sớm hơn:
- Triệu chứng toàn thân: Khi lượng tế bào máu khỏe mạnh giảm, cơ thể bắt đầu biểu hiện mệt mỏi, hoa mắt, chóng mặt, da nhợt nhạt. Người bệnh thường sụt cân nhanh, chán ăn và giảm khả năng tập trung. Những dấu hiệu này phản ánh tình trạng thiếu máu do tủy xương bị tổn thương.
- Triệu chứng do xuất huyết: Sự suy giảm tiểu cầu khiến cơ thể dễ bị chảy máu, đặc biệt ở niêm mạc và da. Người bệnh có thể bị bầm tím tự phát, chảy máu cam, chảy máu chân răng hoặc xuất huyết dưới da. Trường hợp nặng, xuất huyết nội tạng có thể xảy ra, gây nguy hiểm tính mạng.
- Triệu chứng do nhiễm trùng: Vì hệ miễn dịch suy yếu, người mắc bạch cầu cấp rất dễ nhiễm trùng tái diễn. Các biểu hiện thường gặp gồm sốt cao, ớn lạnh, viêm họng kéo dài, viêm phổi, nhiễm trùng da hoặc đường tiết niệu. Nhiễm trùng kéo dài là dấu hiệu cho thấy hệ miễn dịch đã bị tổn thương nghiêm trọng.
- Biểu hiện khác: Ngoài các triệu chứng trên, người bệnh còn có thể bị sưng hạch cổ, gan và lách to do tế bào ung thư xâm lấn. Một số trường hợp còn xuất hiện đau xương, đau khớp hoặc phì đại nướu răng - đặc trưng ở thể bạch cầu cấp dòng tủy.

Phương pháp chẩn đoán bệnh bạch cầu cấp
Chẩn đoán sớm đóng vai trò then chốt trong điều trị bạch cầu cấp. Bác sĩ sẽ tiến hành thăm khám lâm sàng kết hợp xét nghiệm máu và tủy xương để xác định chính xác tình trạng bệnh. Cụ thể:
Xét nghiệm cơ bản
Các xét nghiệm cơ bản giúp sàng lọc và phát hiện bất thường ban đầu gồm:
- Công thức máu (CBC): Kiểm tra số lượng tế bào máu và phát hiện sự xuất hiện của tế bào non.
- Phết máu ngoại biên: Quan sát hình thái tế bào máu để phát hiện dấu hiệu bất thường.
Xét nghiệm chuyên sâu
Để xác định chính xác loại bạch cầu cấp và giai đoạn bệnh, bác sĩ có thể chỉ định các xét nghiệm chuyên sâu như:
- Tủy đồ: Lấy mẫu tủy xương để xác định tỷ lệ tế bào blast.
- Xét nghiệm di truyền - phân tử: Phát hiện các đột biến gen như FLT3, NPM1, BCR-ABL… là các đột biến này có ý nghĩa trong lựa chọn thuốc điều trị đích.
- Xét nghiệm miễn dịch học: Sử dụng kỹ thuật Flow Cytometry giúp phân loại chính xác dòng tế bào bạch cầu.

Phương pháp điều trị bệnh bạch cầu cấp hiện nay
Điều trị bạch cầu cấp đòi hỏi phác đồ kết hợp nhiều phương pháp, tùy thuộc vào thể bệnh, độ tuổi và sức khỏe tổng quát của người bệnh. Cụ thể:
Hóa trị
Đây là phương pháp điều trị chính cho hầu hết các trường hợp bạch cầu cấp. Hóa trị giúp tiêu diệt tế bào ung thư trong máu và tủy xương qua 3 giai đoạn:
- Tấn công: Tiêu diệt tế bào bạch cầu ác tính trong máu.
- Củng cố: Ngăn ngừa tái phát sau giai đoạn đầu.
- Duy trì: Kiểm soát lâu dài, giảm nguy cơ bệnh quay trở lại.
Trong quá trình điều trị, người bệnh có thể gặp tác dụng phụ như mệt mỏi, rụng tóc, buồn nôn, song đây là phản ứng tạm thời và thường được kiểm soát bằng thuốc hỗ trợ.

Ghép tủy xương
Ghép tủy là giải pháp hiệu quả cho bệnh nhân tái phát hoặc không đáp ứng hóa trị. Phương pháp này thay thế tủy xương bị tổn thương bằng tế bào gốc khỏe mạnh, giúp phục hồi khả năng tạo máu. Tuy nhiên, quá trình này đòi hỏi sự tương thích cao giữa người cho và người nhận, cũng như điều kiện theo dõi nghiêm ngặt.
Liệu pháp nhắm trúng đích và miễn dịch
Nhờ tiến bộ y học, liệu pháp nhắm trúng đích và miễn dịch đang mở ra hy vọng mới cho người bệnh bạch cầu cấp.
- Liệu pháp nhắm trúng đích: Dùng thuốc tác động trực tiếp vào các gen đột biến, ví dụ như Imatinib hoặc Midostaurin.
- Liệu pháp miễn dịch: Sử dụng tế bào miễn dịch (CAR-T) hoặc kháng thể đơn dòng giúp cơ thể nhận diện và tiêu diệt tế bào ung thư chính xác hơn.
Bạch cầu cấp là bệnh lý ác tính nguy hiểm, song hoàn toàn có thể kiểm soát nếu được phát hiện sớm, điều trị đúng phác đồ và theo dõi chặt chẽ. Người bệnh cần tuân thủ hướng dẫn của bác sĩ, không tự ý bỏ dở điều trị, đồng thời duy trì lối sống khoa học, chế độ dinh dưỡng cân bằng để tăng cường khả năng phục hồi.
:format(webp)/470051785_8767135473405056_691967411107495592_n_6b2bbff755.png)
:format(webp)/467434554_545745841560409_1066418224364723785_n_560a494f9c.png)
/tang_bach_cau_don_nhan_nhiem_khuan_nguyen_nhan_va_cach_dieu_tri_1_72a5068286.png)
/benh_bach_cau_lympho_man_tinh_trieu_chung_va_huong_xu_ly_1_202fc77a1b.png)
/bach_cau_trung_tinh_giam_nguyen_nhan_trieu_chung_va_cach_dieu_tri_1_51e6297fd2.png)
/bach_cau_lympho_vai_tro_va_y_nghia_khi_tang_hoac_giam_1_072e08bcda.png)
/xet_nghiem_bach_cau_la_gi_chi_so_binh_thuong_va_y_nghia_trong_chan_doan_benh_9aa1d61a6c.jpg)